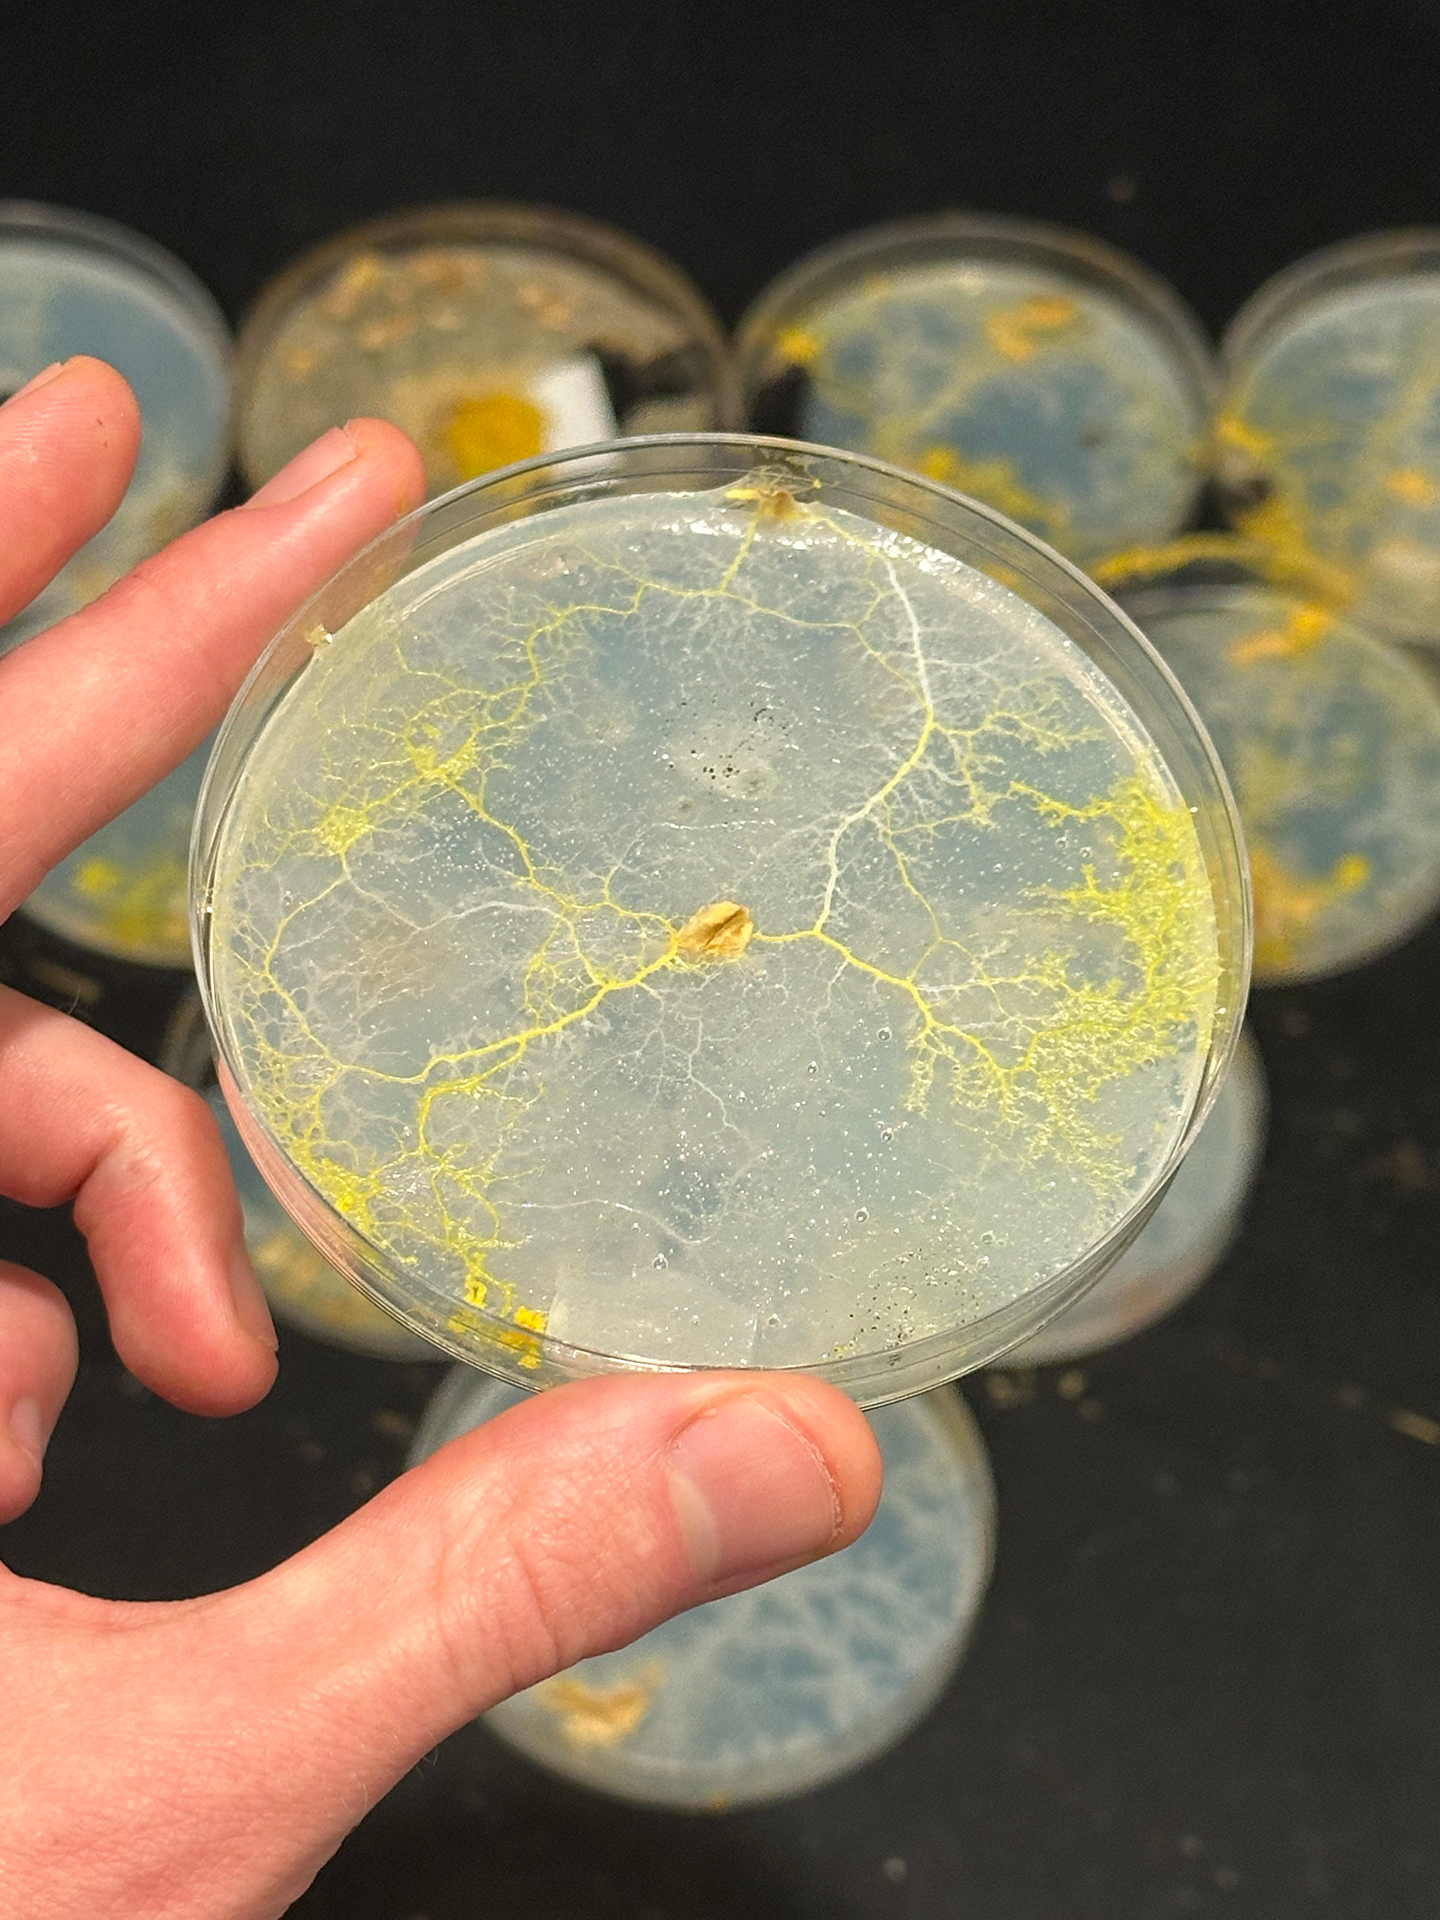
Celebrating The Last of Us Day 2024

Celebrating The Last of Us Day 2024
New Steam offerings, merchandise, and more honoring The Last of Us and its incredible community, 11 years on.
We here at Naughty Dog team are thrilled to continue celebrating The Last of Us Day with our incredible, passionate TLOU community. In our 11th year of honoring the franchise, our talented teams, and the tremendous group of fans that have supported us, we’re reflecting both on where the franchise started and how far it’s grown.
We’ve been so overjoyed by your reaction to The Last of Us Part II Remastered this past year. Since January, we’ve loved watching you all tackle nail-biting No Return runs, show off your musical talents in Guitar Free Play, and go behind-the-scenes of development with the Lost Levels. Seeing new and old fans alike gain a deeper appreciation for our team’s work, and find new elements of our games to love, motivates our team to continue creating amazing experiences for you.
For TLOU Day 2024, we’re excited to offer a few new goodies for more fans on PC, announcing some new merchandise, and more. Read on for a breakdown of this year’s celebrations.
HBO Season 2 The Last of Us Day Teaser
Season 2 of HBO’s The Last of Us is coming next year, and after your incredible reaction to the first look just a few weeks ago, we and HBO couldn’t wait to show you more of what’s in store. And thankfully, the wait wasn’t that long! Be sure to watch the jam-packed new TLOU Day Teaser for season two of the returning series.
Let us know what your favorite moment from the trailer is on social media – what scenes you recognize from the game, and what new glimpses you caught, too.
TLOU Part I on PlayStation Plus
While you wait for season 2 in 2025, maybe you want to refresh your memory on the story that started it all – or play it for the first time. We have exciting news for PlayStation Plus subscribers at the Extra and Premium Tiers!
The Last of Us Part I is now available as part of the PS Plus libraries at those tiers.* PlayStation 5 players can jump into our from-the-ground-up remake of the original TLOU. Explore the story of Joel and Ellie’s journey across America, enjoying the full campaign and the Left Behind standalone DLC, both with remade visuals, improved gameplay, and 3D audio enhancements.
New Steam Assets
It's been a joy to see so many new players fall in love with The Last of Us Part I since its launch on PC in 2023. To celebrate TLOU Day this year, we wanted to offer a host of new Steam bonuses.
Starting today, Steam owners can purchase new TLOU-themed animated stickers, avatars, and more via the Steam Points Shop. And among our new offerings is a The Last of Us-themed Steam Deck Startup Movie, featuring a take on the iconic The Last of Us’ original opening.

But the mold featured in this new startup animation was home grown by our own Graphic Designer Jason Ferry. Here was his creative approach to sprouting, capturing, and adapting a real-life mold into this intro:
“The Steam Deck animation is a timelapse of slime mold growing over a few days. I wanted the mold to grow into the shape of the Steam Deck logo so it felt more tactile and less like generic stock footage. To do this, I tried a bunch of different methods from 3D printing mazes to creating cookie cutters in the shape of the logo, but the best results came when the mold was grown upside down and baited with an oat flake.”
You can also check out some of Jason’s in-progress development of the mold in the photos below:

New The Last of Us Merchandise
We’re excited to reveal a few new offerings commemorating TLOU Day 2024. The first Youtooz The Last of Us collectibles are available for preorder starting later today. We’re thrilled to showcase the first in this new line of TLOU figures with Joel and the Clicker.

In our continued partnership with our friends at Gallery Nucleus, they are offering a new limited-run print that was previously showcased as part of last year’s TLOU 10th anniversary gallery show.

Additionally, new Joel and Ellie posable figures are now available for preorder from Spin Master.
And last but not least, a whole new set of TLOU merchandise is available at the PlayStation Gear store**. Check out the Seraphite jacket replica, the Look for the Light t-shirt, a cassette tape ornament, and a giraffe plushie keychain.

Thank you so much for celebrating The Last of Us Day for over a decade with us. It continues to be our team’s great honor to know how many of you have been moved by the games we make. The beautiful fan art, wonderfully detailed cosplay, and so much more you share stuns us daily, and we’re so thankful for your support.
If you haven’t already, be sure to check out our The Last of Us Day photo mode spotlight results – thank you to everyone who participated – and as always, we’re grateful to continue celebrating TLOU Day alongside you.
*Game Catalog varies over time, region/country, and plan. PS Plus is subject to a recurring subscription fee taken automatically until cancellation. Terms apply: play.st/psplus-usageterms.
**Availability limited to certain countries. See PlayStation Gear store for details.




